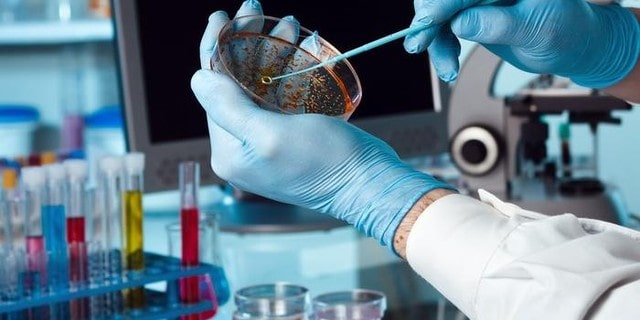
Студент из Конго госпитализирован в больницу с малярией

Первый в текущем году случай завозной малярии зарегистрирован на территории Харьковской области. Об этом рассказали в пресс-службе регионального Центра лабораторных исследований министерства здравоохранения Украины.
Сообщается, что заболевший – студент одного из вузов, которые приехал из Конго на учебу в Харьков. Инфекционное заболевание у него заподозрили во время медицинского обследования в студенческой больнице. Исследование биоматериала специалистами лаборатории подтвердили опасения – парень завез из своей страны малярию. Его госпитализировали в городскую больницу № 31. По месту жительства иностранного студента было проведено эпидемиологическое расследование, а также осуществлены необходимые санитарно-профилактические мероприятия.
Как известно, в прошлом году малярию в Харьков завезла местная жительница, побывавшая в одной из африканских стран.